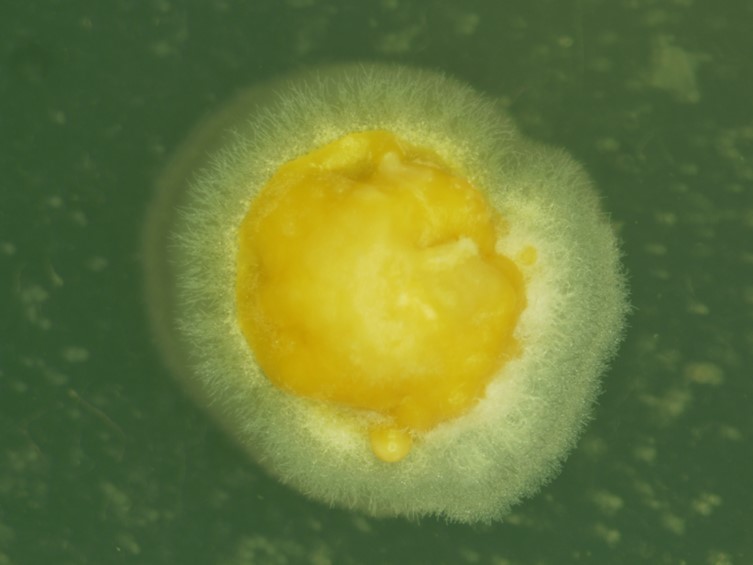

Holotype:
THAILAND, Chaiyaphum Province, Phu Khiao Wildlife Sanctuary, 15 Oct. 2005, R. Ridkaew, B. Thongnuch, K. Tasanathai, holotype BBH 17305, ex-type living culture BCC 19769.
Habitat:
Underside of dicotyledonous leaves.
Host:
Scale insect nymphs (Hemiptera).
Description:
 Sexual morph: stromata flattened pulvinate, sometimes surrounded by a membranous hypothallus; up to 5 mm diam and 2 mm high, dark orange to golden yellow.
Sexual morph: stromata flattened pulvinate, sometimes surrounded by a membranous hypothallus; up to 5 mm diam and 2 mm high, dark orange to golden yellow.  Perithecia 400-520 × 150-200 μm, crowded, immersed, elongate flask-shaped, ostioles slightly projecting, translucent.
Perithecia 400-520 × 150-200 μm, crowded, immersed, elongate flask-shaped, ostioles slightly projecting, translucent.  Asci 195-220 × 8-12 μm, cylindrical, with cap approx. 4-6 thick.
Asci 195-220 × 8-12 μm, cylindrical, with cap approx. 4-6 thick.  Ascospores disarticulating into 12.5-17.5 × 2-3 μm part-spores inside the ascus, cylindrical with somewhat rounded ends.
Ascospores disarticulating into 12.5-17.5 × 2-3 μm part-spores inside the ascus, cylindrical with somewhat rounded ends.  Asexual morph: stroma flattened pulvinate.
Asexual morph: stroma flattened pulvinate.  Conidiomata orifice scattered or circularly arranged, ultimately hidden by the orange-yellow mass or extruded
Conidiomata orifice scattered or circularly arranged, ultimately hidden by the orange-yellow mass or extruded  conidia, oval or elongate flask-shaped, up to 430 μm deep, up to 100 diam.
conidia, oval or elongate flask-shaped, up to 430 μm deep, up to 100 diam.  Conidiogenous cells cylindrical, up to 25 μm long, 1-2 μm wide. Conidia 16-17 μm × 2.5-3.5 μm, cylindrical narrow, tapering slightly towards the ends.
Conidiogenous cells cylindrical, up to 25 μm long, 1-2 μm wide. Conidia 16-17 μm × 2.5-3.5 μm, cylindrical narrow, tapering slightly towards the ends.  Paraphyses present, linear, filiform, up to 90 μm long, 1-2 μm wide.
Paraphyses present, linear, filiform, up to 90 μm long, 1-2 μm wide.
Culture characteristics:
Colony on PDA grew slowly, to approx. 5 mm diam after 4 wk at 20°C. The stromatic colony derived from germinating ascospores or conidia formed a compact mycelium. The conidial mass yellow to orange yellow appearing as abundant slimy masses scattered over the surface of stromatic colony.
Colony on PDA grew slowly, to approx. 5 mm diam after 4 wk at 20°C. The stromatic colony derived from germinating ascospores or conidia formed a compact mycelium. The conidial mass yellow to orange yellow appearing as abundant slimy masses scattered over the surface of stromatic colony.
Reference:
Li GJ, Hyde KD, Zhao RL, et al. (2016). Fungal diversity notes 253–366: taxonomic and phylogenetic contributions to fungal taxa. Fungal Diversity 78: 1–237.
DOI: https://doi.org/10.1007/s13225-016-0366-9Species |
Strain |
Compound |
Pubchem CID |
Biological activity |
Reference |
|---|
|
Strain |
LSU | RPB1 |
|---|---|---|
| BCC 19769 | KT880502 | KT880506 |
| BCC 19773 | KT880503 | KT880507 |